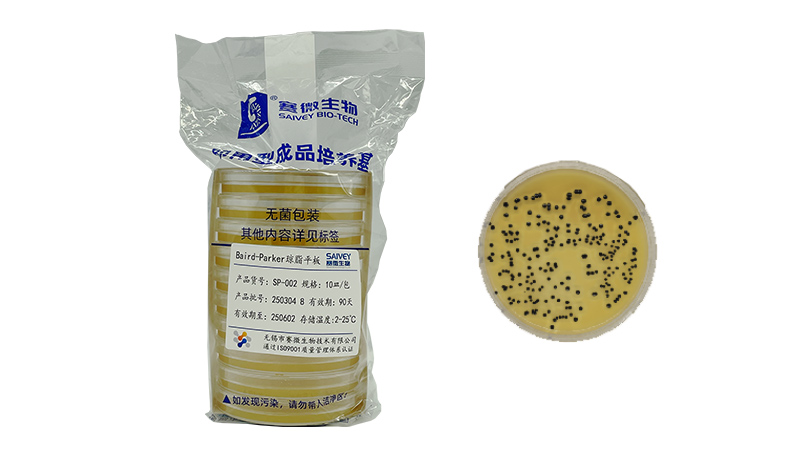
产品一.jpg
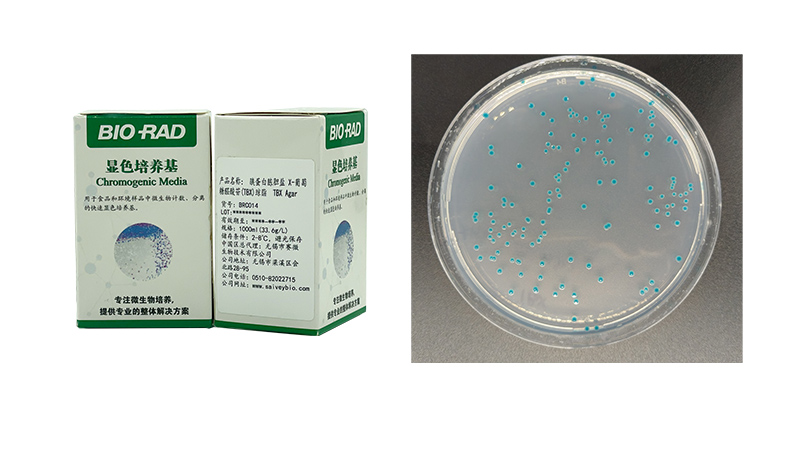
产品三.jpg
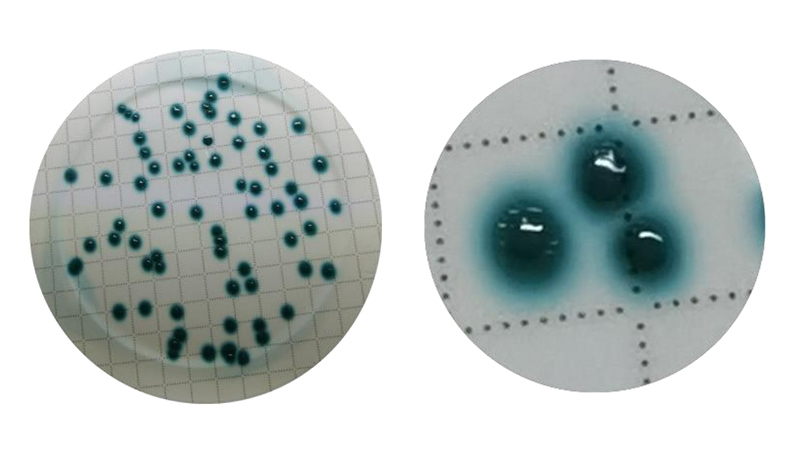
产品四.jpg
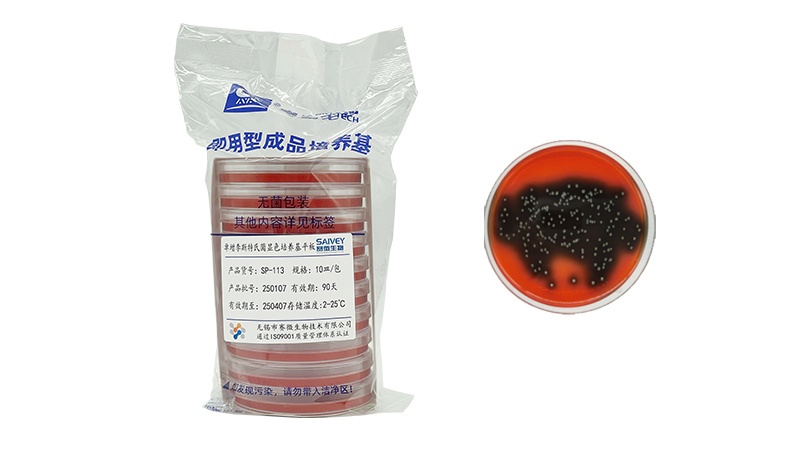
产品五.jpg

作为食品安全技术领域规模最大、人气最旺和最受欢迎的行业盛会之一,CBIFS第十八届食品安全技术论坛暨太平洋食安展将于2026年4月9日-10日在苏州举办。
赛微生物确认参展本次论坛,欢迎各位领导专家和客户朋友参观交流、合作洽谈!


无锡市赛微生物技术有限公司
无锡市赛微生物技术有限公司是集研发、生产和销售于一体的高科技企业。公司立足长三角,辐射全国,为食品、医药、检验检疫等领域提供微生物检测产品及技术服务。
公司的现有产品涵盖了食品微生物检验、医药工业环境监测、公共卫生检验三大领域。主要品类有:预灌装平板培养基、预灌装液体袋装增菌培养基、预灌装管装培养基,超200个品种。
公司拥有600平米的万级洁净生产车间和装备完善的检验实验室,引进德国Systec培养基制备器、瑞士IBS培养基分装器等国外先进设备,配有全自动平板灌装线,全自动试管分装线。
公司已通过GB/T 19001质量管理体系认证,拥有一流技术人员和一整套严格的品质监控体系。公司微生物检测实验室已通过ISO17025 CNAS认可认证,实验室的检测能力高度的认可,确保培养基的质量。
公司拥有一支优秀的售后服务团队,全部拥有相关专业本科学历以上;同时公司也于食品、医药、卫生检验等行业相关专家保持良好的合作,致力于为客户提供最及时、最专业的整体解决方案。
电话:0510-82022715
地址:无锡市北塘区光电新材料科技园会北路28-95
网址:www.saiveybio.com
Baird-Parker琼脂平板
• 省时省力: 省去了自己制备培养基、灭菌和倒平板的过程。
• 一致性和可靠性: 同批次即用型平板的配方和灭菌条件高度一致,减少实验中的人为误差。
• 减少污染风险: 预制平板在无菌条件下生产和包装,减少污染风险。
• 多种规格和类型可选: 包括不同的培养基配方、不同的抗生素和不同规格的平板,只需根据需求购买和使用,满足各种实验需求。
• 可定制: 可根据客户需求,为客户定制特殊的平板 。
Baird-Parker琼脂是食品安全领域检测金黄色葡萄球菌的 “金标准”培养基,广泛应用于生产、监管和科研环节。

Fraser增菌肉汤(FB1)
• 省时省力: 省去了自己制备培养基、灭菌的过程。
• 一致性和可靠性: 同批次培养基的配方和灭菌条件高度一致,减少实验中的人为误差。
• 减少污染风险: 预制培养基在无菌条件下生产和包装,减少污染风险。
• 可定制: 可根据客户需求,为客户定制特殊的培养基 。
Fraser增菌肉汤 主要用于食品中单核细胞增生李斯特氏菌 的选择性增菌培养,是食品安全检测的关键步骤。
TBX显色培养基
• 高特异性显色反应:含特定底物,大肠杆菌分泌的β-葡萄糖醛酸酶可分解该底物,生成蓝色/蓝绿色菌落,直接区分大肠杆菌与其他菌群。
• 强选择性抑制杂菌:添加胆盐和抗生素,抑制革兰氏阳性菌和部分非目标革兰氏阴性菌,提高目标菌检出率。
• 快速检测与简化流程:无需额外生化确认,24小时内通过菌落颜色即可初步判定大肠杆菌,显著缩短检测时间。
TBX平板通过显色反应+选择性抑制,实现大肠杆菌的快速、精准检测,是食品安全和卫生监控的高效工具。
铜绿假单胞菌显色培养基
• 高选择性: 培养基中添加了特异性抑制剂,可抑制大多数非目标菌的生长,提高铜绿假单胞菌的分离率。
• 适应复杂样本:适用于含杂菌较多的样本(如粪便、痰液、环境拭子等)。
• 显色鉴别:铜绿假单胞菌的菌落通常呈现特定颜色,因其分泌的色素或酶与培养基中的显色底物反应所致。
• 灵敏度高:可检测低浓度的铜绿假单胞菌,适用于临床或环境样本中的微量病原体筛查。
铜绿假单胞菌显色培养基在食品安全领域可用于快速检测食品、饮用水中的污染,通过特异性显色直观鉴别目标菌,提升监控效率。
李斯特氏菌显色培养基平板
• 快速直观鉴定:通过特异性显色反应,显著缩短鉴定时间,减少生化确认步骤。
• 高选择性:含选择性抑制剂,抑制杂菌,提高目标菌(尤其是单核细胞增生李斯特氏菌)的分离率。
• 灵敏度高:可检测低污染样本,适用于复杂基质(如食品、环境拭子)的直接筛查。
• 简化操作:无需额外染色或复杂试验,菌落颜色即可初步区分李斯特氏菌属。
李斯特氏菌显色培养基平板可快速、特异性地检测食品中的单核细胞增生李斯特氏菌,通过显色反应(如蓝绿色菌落)实现直观鉴别,显著提升食品安全监测效率。该培养基适用于乳制品、即食食品等样品的检测。

一次性无菌培养皿
• 选用高透明聚苯乙烯材料,超精密模具及全自动化生产工艺,本产品广泛应用于细胞、细菌培养和药敏试验等。适合实验室接种、划线、分离细菌等操作。
• 产品晶莹剔透、厚度均匀,皿底平整光洁、无畸变,使定量分析更准确。
• 经特殊改进,使皿盖和皿底强度增加,同时提高平整度,增加培养皿内壁
的吸附性。
• 经真空等离子表面处理(TC处理)的培养皿,细胞贴壁优良。
• 皿盖内侧凸点,满足气体交换的需要。
• 经环氧乙烷灭菌。
一次性无菌培养皿是食品安全微生物检测的核心工具,通过标准化培养将看不见的微生物污染转化为可视化的科学数据,为从生产到消费的全链条卫生监控提供关键依据,是保障食品安全不可缺少的工具。




